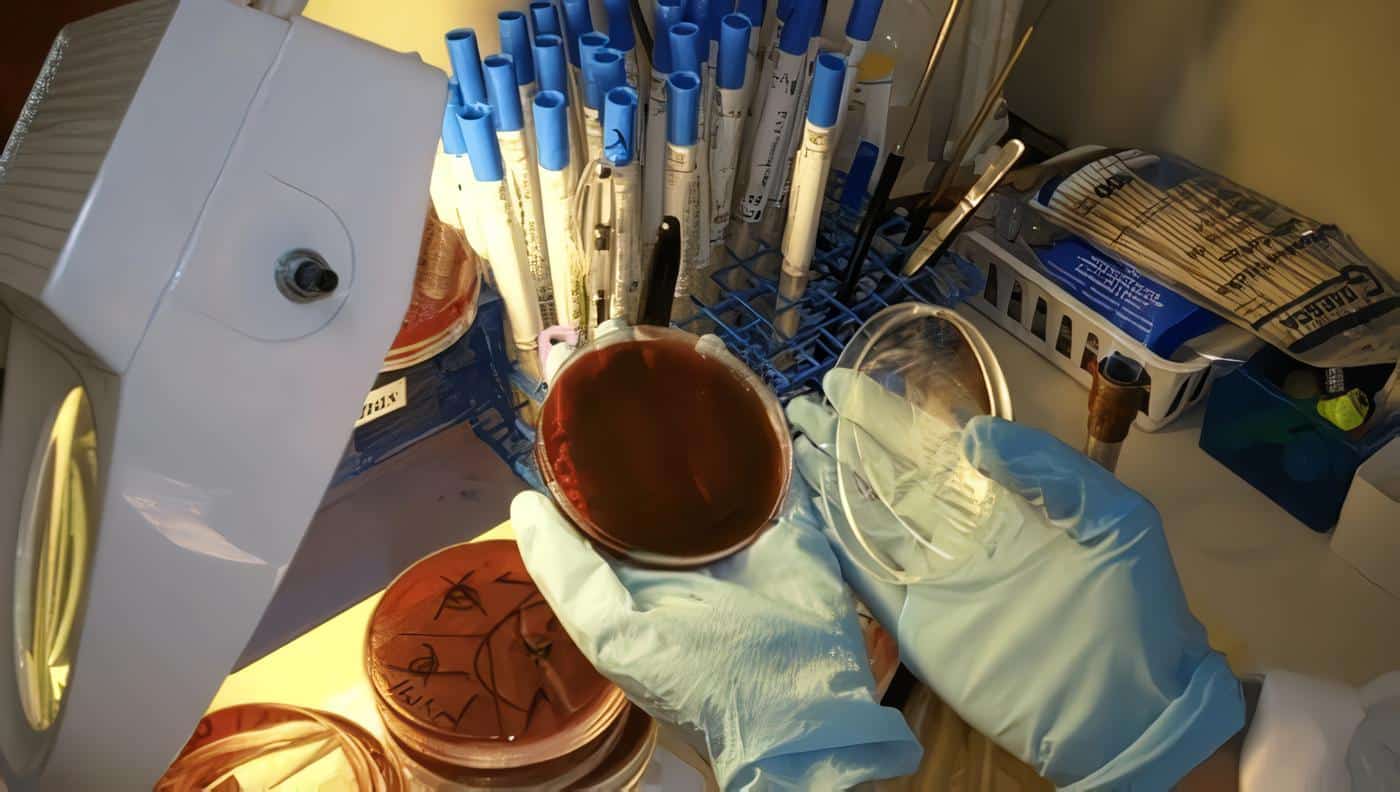

Capitulo I. Disposiciones Generales
ARTÍCULO 12. El ejercicio de la Profesión de Bacteriología debe ser guiada por criterios, conceptos y elevados fines que propendan a enaltecer su profesión; por lo tanto, están obligados a ajustar sus actuaciones profesionales a las disposiciones de las siguientes normas que constituyen su Código de Bioética Profesional.
Capitulo II. Deberes Frente a las Condiciones Específicas de la Profesión de Bacteriología
ARTÍCULO 13. Son deberes frente a las condiciones específicas de la profesión de Bacteriología:
a) Cumplir y hacer cumplir todos los reglamentos exigidos por la ley que ampara el ejercicio profesional tales como: obtener el título universitario debidamente registrado, prestar el servicio social obligatorio, mantener vigente la tarjeta de inscripción profesional y si posee laboratorio mantener actualizada la licencia de funcionamiento;
b) Tener plena conciencia de su responsabilidad profesional que implique permanentemente actualización científica, tecnológica y administrativa para aplicar dichas innovaciones en su desempeño profesional;
c) Ser responsable de los daños y perjuicios que causen sus errores y estar obligado a su reparación;
d) Ejercer su profesión en condiciones de serenidad y juicio que garanticen la precisión de los análisis;
e) Atender el llamado que se le haga cuando:
– Se trate de un caso de urgencias.
– No hubiese otro profesional en la localidad o institución;
f) Ajustar su conducta a normas de dignidad, honradez y seriedad;
g) Guardar el secreto inherente a la profesión;
h) Ser responsable del informe que ha sido certificado con su firma;
i) Realizar un estricto control de calidad de todos los elementos, reactivos, equipos y técnicas usadas en el laboratorio;
j) Promover el respeto por la persona del bacteriólogo dentro y fuera de la comunidad científica y profesional;
k) No hacer al paciente comentarios que despierten su preocupación, y mucho menos diagnósticos de la enfermedad que no son de su competencia;
l) Establecer comunicación con el profesional que solicite los servicios al laboratorio siempre que la situación del paciente lo requiera;
m) Exigir el derecho a recibir una digna remuneración por su trabajo lo cual constituye un medio normal de subsistencia;
n) Evitar que profesionales ajenos a la bacteriología y laboratorio clínico se lucren de este a expensas de convertir la actividad asistencial del laboratorio en un negocio personal;
o) Comprometer su tiempo laboral únicamente con el número de exámenes que pueda realizar con garantía de calidad para el diagnóstico;
p) No utilizar el registro profesional para amparar diagnósticos hechos por terceros que no sean competentes en el ejercicio de sus funciones y evitar cualquier mediación que lo instrumentalice para obtener ganancias deshonestas para terceros ajenos a la directa actividad profesional;
q) Tener plena conciencia de los riesgos que conlleva el ejercicio de la profesión y en consecuencia observar permanentemente las normas de bioseguridad requeridas.
Capitulo III. Deberes Frente al Paciente
ARTÍCULO 14. Son deberes frente al paciente:
a) Atender con celo y amabilidad a todo paciente que solicite sus servicios bajo las normas éticas que exige la dignidad de la persona, cualquiera que sea su nacionalidad, raza, posición social e ideas políticas o religiosas;
b) No realizar exámenes innecesarios a los pacientes con fines netamente comerciales;
c) No permitir la realización de análisis clínicos por el personal auxiliar que no es profesionalmente competente;
d) Velar para que las tarifas de los servicios prestados sean justas y reflejen los costos del rigor científico y de la calidad requerida;
e) Mantener su laboratorio con el decoro y la responsabilidad que requiere el ejercicio profesional;
f) No negar los servicios profesionales por temores a contagio o a situaciones desagradables;
g) Entregar en forma clara, precisa y oportuna los resultados sin causar demora que perjudique a los pacientes;
h) Certificar con su firma y número de registro cada uno de los análisis realizados;
i) Dar al paciente instrucciones claras y precisas sobre las condiciones adecuadas en la toma de muestras, para garantizar la calidad y veracidad de los resultados.
Capítulo IV. Deberes Frente a las Instituciones Públicas o Privadas en las Cuales el Bacteriólogo Presta sus Servicios
ARTÍCULO 15. Son deberes frente a las instituciones públicas o privadas en las cuales el Bacteriólogo presta sus servicios:
a) Conocer las leyes, las normas técnicas y los manuales de procedimientos para ajustar a ellos la prestación adecuada de sus servicios;
b) No malgastar ni extremar la economía de materiales e insumos de laboratorio en perjuicio económico de la empresa o usuarios;
c) Cumplir a cabalidad sus deberes profesionales, horarios y demás compromisos razonables a que está obligado en la institución donde presta sus servicios.
d) Exigir el suministro de materiales, equipos y reactivos con calidad certificada que garantice la confiabilidad de los resultados;
e) Mantener al día estadísticas y consumos de laboratorio;
f) No realizar exámenes gratis a expensas económicas de la entidad donde presta sus servicios, perjudicando a terceros;
g) No aprovechar su vinculación con la institución para canalizar pacientes hacia su laboratorio particular o a otros laboratorios produciendo así una competencia desleal;
h) No propiciar con su conducta escándalos que incidan en detrimento de la institución donde labora y con menoscabo de la comunidad;
i) Cuidar las pertenencias de la institución dándole buen manejo y evitar su deterioro;
j) No desempeñar cargos remunerados en los cuales sus horarios sean coincidentes, salvo las excepciones, contempladas en la ley vigente.
k) No aceptar cargos laborales que superen su capacidad física, mental, científica y profesional;
l) No retirarse del sitio de trabajo sin haber concluido en forma responsable el trabajo iniciado y al cual está comprometido;
m) No ser infidente con los conocimientos, tecnologías, aspectos económicos y administrativos y demás particularidades de la institución donde labora.
Capitulo V. Deberes Frente a los Profesionales de Bacteriología
ARTÍCULO 16. Son deberes frente a los profesionales de Bacteriología:
a) Ser solidario con los profesionales de Bacteriología y demás integrantes del equipo de salud, evitando comentarios sin justificación que afecten su imagen y crédito personal;
b) Reconocer y respetar sus valores humanos y profesionales;
c) Denunciar a la instancia competente toda práctica que conlleve al ejercicio ilegal e inadecuado de la profesión;
d) Rechazar toda forma de chantaje en su ejercicio profesional como sería el recibir u ofrecer porcentajes por remisión de pacientes;
e) No realizar procedimientos o modificaciones de los exámenes que incidan en disminución de la calidad de los resultados, so pretexto de hacer ahorros, de disminuir costos, de ampliar ganancias;
f) Compartir con los profesionales de Bacteriología nuevos conocimientos científicos y tecnológicos, contribuyendo así a su progreso profesional;
g) Ser deferente con los profesionales de Bacteriología en prestarles un servicio profesional a menor costo;
h) Promover el análisis permanente de las normas bioéticas que regulan el ejercicio profesional.
Capitulo VI. Deberes Frente a Los Subalternos
ARTÍCULO 17. Son deberes frente a los subalternos:
a) Ofrecer un trabajo digno y justo, respetando su seguridad y sus derechos;
b) No permitir al personal subalterno la solución de problemas que requieren el juicio y la participación exclusiva del Bacteriólogo;
c) Cumplir con las normas legales en relación con la contratación de servicios;
d) Velar por el crecimiento personal, el mejoramiento laboral y por la educación continuada de sus subalternos;
e) Ser solidario con los subalternos en situaciones que requieren especial apoyo de consejería profesional;
f) Mantener con el equipo de trabajo excelentes relaciones en las que primen la comprensión, la tolerancia y el respeto;
g) Por encima de cualquier concepto organizacional que implique jerarquías laborales, está la visión humanizante que reconoce la dignidad de cada una de las personas integrantes de un equipo de trabajo. En consecuencia, hay que despertar sentimientos de comunión con los subalternos y estar muy atentos a compartir solidariamente sus necesidades personales y familiares.
Capitulo VII. Deberes Frente a sus Compromisos Docentes
ARTÍCULO 18. Son deberes frente a sus compromisos docentes:
a) Permanecer constantemente actualizado en la ciencia de su especialidad, en la constante renovación tecnológica y en los procesos pedagógicos;
b) Valorar las actitudes y contribuciones del estudiante, como interlocutor válido importante del sistema enseñanza-aprendizaje, respeto sus patrones culturales, religiosos, políticos y raciales;
c) Cultivar la sensibilidad social en la docencia para que los estudiantes adquieran un compromiso transformador del país en búsqueda de justicia y de oportunidades de bienestar para todos los colombianos;
d) Formar al estudiante con mentalidad y actitudes interdisciplinarias para que integre eficientemente en equipos de trabajo en la salud;
e) Motivar al estudiante para que sea agente activo de su propia formación, dándole herramientas científicas y tecnológicas y estimulando su libertad e imaginación creativa en los procesos de investigación;
f) Comunicar verbalmente y con actitudes personales la jerarquía de valores éticos y morales que conduzcan a un crecimiento de la persona y a un futuro ejercicio digno de la profesión;
g) Vincular íntimamente las tareas de docencia con las de investigación científica, de tal manera que la enseñanza sea fruto de lo que ha investigado y a su vez se esfuerce en investigar porque le motiva correr las fronteras del conocimiento y co mpartirlo con sus estudiantes;
h) Promover la información de líderes a través de su ejemplar ejercicio profesional;
i) Cultivar en sus alumnos los valores que le permitan un permanente crecimiento personal y profesional.
Capitulo VIII. Deberes Frente a la Investigación
ARTÍCULO 19. Propósito De La Investigación En Beneficio De Los Seres Humanos. El propósito de la investigación en beneficio de los seres humanos y sin detrimento de los ecosistemas, debe ser el de mejorar los procedimientos diagnósticos, terapéuticos y preventivos y la comprensión de la etiología y patogenia de las enfermedades. De ninguna manera puede ser propósito de las investigaciones científicas buscar hacer daño a los seres humanos y al hábitat, como es el caso de fabricar armas biológicas y microorganismos para el control biológico de la agricultura que se liberen causando perjuicios imprevisibles.
Simultáneamente con ser profesional de la bacteriología, hay que tomar alta conciencia de que se es miembro de la comunidad científica, razón por la cual es un imperativo ético participar activamente en investigaciones y en asociaciones de ciencia y tecnología.
En el orden ético de la investigación, primeramente se debe proceder con métodos alternativos, en segundo lugar con animales y finalmente con humanos si el protocolo lo requiere.
ARTÍCULO 20. Investigación con Métodos Alternativos. Los procedimientos alternativos comprenden métodos que no utilizan directamente tejidos vivos. Estos incluyen modelos matemáticos y simulaciones gráficas y computarizadas de las relaciones entre estructura y función de los organismos vivos, basados en las propiedades fisicoquímicas de dichos organismos. En cuanto se trate de aspectos epidemiológicos y de salud pública, la bioestadística es un instrumento alternativo de investigación científica de gran importancia. Por otra parte, el acopio de información tanto bibliográfica como telemática, permite establecer políticas de investigación alternativa y evita repetir inoficiosamente lo que ya se ha investigado en otras instancias.
Es un imperativo ético que las instituciones universitarias y aquellas empresas que se dedican a la investigación científica dispongan de los métodos alternativos para evitar que se proceda directamente a utilizar organismos vivos (cultivos celulares, microorganismos, plantas, animales y humanos) en estudios científicos.
ARTÍCULO 21. Investigación en Animales. La experimentación en animales ha permitido grandes avances en conocimientos biológicos y del bienestar del hombre y de los animales, en particular en los que respecta al tratamiento y prevención de enfermedades.
Es inevitable realizar investigaciones en ciertas especies de animales para descubrir métodos de prevención y tratamiento de enfermedades para las que aún no existen medidas adecuadas de control, sobre todo enferm edades no transmisibles.
Desde el punto de vista bioético, toda investigación científica en animales debe inscribirse en el cumplimiento de la declaración universal de los derechos de los animales, de la ONU y de las normas internacionales para la investigación biomédica con animales vigente.
ARTÍCULO 22. Principios Básicos Para Investigación En Animales. Son principios básicos para investigaciones en animales:
a) Cuando sea posible en vez de animales deben emplearse modelos matemáticos, simulacros en computador y sistemas biológicos in vitro;
b) Los experimentos con animales sólo deberán realizarse cuando se haya comprobado debidamente su interés para la salud humana;
c) Debe utilizarse el mínimo número de animales necesarios para obtener resultados científicamente válidos;
d) Los animales empleados para investigación deben mantenerse en las mejores condiciones posibles ambientales, alimentarias y de salud, con asistencia médico-veterinaria de acuerdo con las normas establecidas para garantizar la calidad de los bioterios;
e) Los animales deben recibir alimentos en calidad y cantidad suficiente para sus necesidades y para conservar la salud y tener acceso libre de agua potable, a menos que el objeto del experimento sea estudiar el efecto de las variaciones de estos nutrientes;
f) No someter a ningún dolor, sufrimiento o estrés a los animales del laboratorio. Hacer uso adecuado de anestesia y de calmantes y asegurárseles el restablecimiento de la salud;
g) En caso de sacrificar animales para la investigación científica, compensar a la madre naturaleza con acciones restauradoras y preservativas de la biósfera;
h) El material biológico desechable debe ser debidamente incinerado y cumplir con todos los protocolos de bioseguridad.
ARTÍCULO 23. Investigación Biomédica con Seres Humanos. Todo adelanto en el ejercicio de la salud humana y en el conocimiento de los procesos fisiológicos y patológicos pertinentes debe necesariamente ser probados en última instancia en sujetos humanos. Este es el sentido que se le da a la expresión “Investigación con sujetos humanos”… La investigación biomédica con seres humanos abarca:
a) El estudio de los procesos fisiológicos, bioquímicos o patológicos, o de las reacciones con una determinada intervención en sujetos sanos o con pacientes bajo tratamiento;
b) Los ensayos clínicos controlados de métodos diagnósticos, profilácticos o terapéuticos en grupos de pacientes de mayor tamaño;
c) Estudios para evaluar las consecuencias de determinadas acciones profilácticas o terapéuticas dentro de una comunidad.
ARTÍCULO 24. Principios Básicos para Investigación con Seres Humanos. Son principios básicos para investigaciones con seres humanos:
a) El bacteriólogo deberá cumplir con los protocolos de consentimiento voluntario informado y advertirle claramente a sus pacientes los objetivos, métodos y beneficios posibles, respetando la posibilidad de abstenerse a participar o de retirarse en cualquier momento de la investigación;
b) Cuando sea absolutamente necesario realizar una investigación con menores de edad y/o minusválidos mentales, siempre es necesario obtener el consentimiento voluntario informado del padre, la madre o tutor legal después de haberles explicado los fines de la investigación, cumpliendo con ellos las mismas condiciones del numeral anterior.
c) A ser posible, evitar hacer investigaciones con personas que estén privadas de la libertad (reclusos) o que estén bajo la subordinación de autoridades superiores (soldados), el consentimiento informado de dichas personas fácilmente puede tener vicios de falta de libertad;
d) Nunca deberá considerarse la participación de mujeres embarazadas o madres lactantes en investigaciones no terapéuticas que puedan exponer a riesgos al feto o al neonato. Se afirma que los bacteriólogos no tienen en su quehacer profesional ser terapeutas directos sino agentes de diagnóstico. Cuando la investigación con un equipo interdisciplinario busque acciones terapéuticas, estas solo se admiten en función de mejorar el estado de salud de la madre o del niño sin perjuicio para el feto o el lactante, sin desfavorecer la capacidad de la madre para lactarlo debidamente;
e) Mientras se puedan hacer investigaciones con pacientes adultos, con quienes se debe llevar rigurosamente el protocolo de consentimiento voluntario informado, conviene evitar realizar investigaciones con menores de edad y/o minusválidos mentales;
f) El investigador nunca puede ser sujeto y objeto de la experimentación al mismo tiempo;
g) El bacteriólogo al realizar trabajos de investigación con comunidades rurales o urbanas, debe explicarles previamente los objetos, métodos y procedimientos. También con las comunidades hay que cumplir lo prescrito en los numerales a), b) y c). Concluido el estudio, está obligado a revertir la información para el beneficio de la comunidad, sin faltar al secreto profesional;
h) Los criterios para la evaluación de las investigaciones dependerán de las políticas de las instituciones y de la estructura orgánica de la profesión de Bacteriología, asegurándose de tener responsabilidad sobre todos los efectos de los estudios;
i) Toda investigación realizada en el campo de la Bacteriología debe ser evaluada previamente y controlada por un comité de ética, el cual considerará si el proyecto de investigación es conveniente desde el punto de vista científico y ético, determinando si los beneficios previstos justifican que el sujeto incurra en cualquier riesgo previsible;< /p>
j) Las investigaciones patrocinadas desde el exterior deben contar con el aval de las autoridades competentes del país anfitrión;
k) Toda información recolectada relativa a personas deben ser protegidas con el carácter de confidencial;
l) El investigador no debe aprovecharse de la indigencia, ignorancia o ingenuidad de las personas que tiene a su alcance para la investigación científica;
m) El investigador tiene el derecho de propiedad intelectual sobre los trabajos que elabora, como también asume la responsabilidad que dichos derechos impliquen.
Capitulo IX. Deberes Frente al País
ARTÍCULO 25. Son deberes frente al país:
a) Participar y promover campañas de salud para grupos marginados de la población;
b) Dar igualdad a las personas de escasos recursos, brindándole atención y servicio oportuno;
c) Ofrecer su concurso y colaboración para prestar servicio voluntario en casos de calamidad pública, problemas comunitarios, en epidemias, accidentes, desastres naturales, etc.;
d) Apoyar campañas de sanidad ambiental que sean pertinentes al ejercicio de su profesión;
e) No escatimar ningún esfuerzo para desempeñarse con el máximo de calidad y eficiencia en el año de servicio social obligatorio, buscando a la vez mayores compromisos con las comunidades urbanas y rurales;
f) Más allá de los compromisos profesionales, la nacionalidad tiene una exigencia de responsabilidad con la suerte del país que invita a militancias políticas, según sus propias convicciones. En este sentido, no sería éticamente correcto eludir acciones vinculantes con la solución de los problemas de Colombia.
Capitulo X. Deberes Frente a las Casas Comerciales
ARTÍCULO 26. Son deberes frente a las casas comerciales:
a) Evitar asumir actitudes serviles ante los representantes de las casas comerciales;
b) Exigir el suministro de reactivos con fechas de vigencia, que garanticen la calidad de su uso;
c) No comprar reactivos vencidos o en mal estado, arguyendo reducción de costo;
d) Mantener un estricto control de funcionamiento de los equipos de laboratorio para lo cual se requiere personal idóneo. La calidad de los análisis depende en gran medida del estado de los equipos y sus insumos;
e) Proteger la reputación de las casas comerciales evitando el mal uso de sus productos, para lo cual hay que recibir un entrenamiento adecuado y llevar con rigor los procedimientos establecidos por las normas técnicas;
f) Evitar compromisos de tipo económico que favorezcan únicamente los intereses personales del profesional.
Capitulo XI. Deberes Frente a la Universidad que lo Formó
ARTÍCULO 27. Son deberes frente a la universidad que lo formó:
a) Tener gran estima a la imagen de la Universidad que le dio su formación y procurar enaltecerla ejerciendo dignamente su profesión;
b) Mantener vínculos, tanto afectivos como científicos con el Alma Máter, buscando coordinar esfuerzos de los egresados a favor de la institución docente;
c) Intégrese al proceso de Educación Continuada para actualizar y reforzar los conocimientos impartidos por la Institución;
d) En el momento de vincular laboralmente a sus colegas, evitar prestarle un mal servicio a su Universidad trayendo a la Institución personas no idóneas, argumentando que son egresados del mismo centro educativo.
Capitulo XII. Deberes Frente a las Asociaciones de su Profesión
ARTÍCULO 28. Son deberes frente a las asociaciones de su profesión:
a) Mantener su afiliación a sociedades de carácter científico y gremial, contribuyendo al desarrollo de la profesión;
b) Cumplir con las normas estatutarias que garanticen el progreso de las asociaciones;
c) Contribuir a la afiliación de nuevos profesionales;
d) Apoyar las actividades científicas, investigativas y gremiales programadas por las asociaciones para el provecho colectivo de la profesión, incluyendo las zonas más apartadas;
e) Como miembro de una asociación auspiciar la integración con asociaciones propias de la profesión o de carácter interdisciplinario;
f) Ser solidario y leal con las asociaciones y darles el apoyo solicitado para el crecimiento de la profesión;
g) Mantener conocimientos actualizados sobre la legislación en salud para hacer oportunas propuestas que protejan los derechos e intereses específicos de la profesión.
Capitulo XIII. De Las Faltas Contra La Bioética Profesional
ARTÍCULO 29. Incurren en faltas contra la Bioética Profesional, los Bacteriólogos de quienes trata el presente código, que violen cualesquiera de los deberes enunciados en la presente ley.
Vigencia
ARTÍCULO 30. La presente ley rige a partir de la fecha de su publicación y deroga todas las disposiciones que le sean contrarias.
El Presidente del honorable Senado de la República,
GERMÁN VARGAS LLERAS.
El Secretario General del honorable Senado de la República,
EMILIO RAMÓN OTERO DAJUD.
El Presidente de la honorable Cámara de Representantes,
ALONSO ACOSTA OSIO.
El Secretario General de la honorable Cámara de Representantes,
ANGELINO LIZCANO RIVERA.
REPÚBLICA DE COLOMBIA – GOBIERNO NACIONAL
PUBLÍQUESE Y CÚMPLASE.
Dada en Bogotá, D. C., a 7 de octubre de 2003.
ÁLVARO URIBE VÉLEZ
El Ministro de la Protección Social,
DIEGO PALACIO BETANCOURT.
La Ministra de Educación Nacional,
CECILIA MARÍA VÉLEZ WHITE.